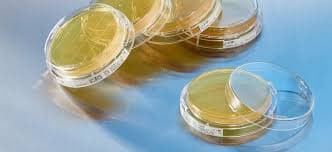
Pharmaceutical Environmental Monitoring Case Study

Environmental Monitoring Pharmaceutical (USP <797> / <800>)
Comprehensive environmental monitoring for pharmaceutical facilities to ensure compliance with USP standards and patient safety.
Request a Quote
Why Get Pharmaceutical Environmental Monitoring?
- Ensure compliance with USP <797> and <800> standards.
- Protect patient safety and medication integrity.
- Monitor air quality in sterile compounding environments.
- Prevent contamination of pharmaceutical products.
- Maintain regulatory compliance and avoid penalties.
Pharmaceutical environmental monitoring is critical for facilities that compound sterile preparations and handle hazardous drugs. Our comprehensive monitoring services ensure your facility meets USP <797> and <800> requirements, protecting both patients and staff while maintaining the highest standards of pharmaceutical safety and quality.
Real Results: Maintaining Sterile Standards
A hospital pharmacy was struggling to maintain USP <797> compliance in their sterile compounding area. Our comprehensive environmental monitoring program identified specific areas where air quality standards weren't being met. With our detailed recommendations and ongoing monitoring, they achieved full compliance and maintained their sterile compounding certification without interruption.

What Our Monitoring Includes
Air Quality
Particle counting and monitoring
Surface Testing
Microbial contamination assessment
Personnel Monitoring
Staff contamination testing
Pressure Monitoring
Room pressure differentials
Temperature & Humidity
Environmental control monitoring
Compliance Reporting
USP standards documentation
Why Choose Environmental Air Solutions?
We're more than just a testing company—we're your partner in safety and peace of mind. Here's why clients trust us:
- Fast Availability: Flexible scheduling, including evenings and weekends.
- Trusted Experience: In business for over 10 years, with hundreds of satisfied clients.
- Affordable Pricing: Transparent quotes with no hidden fees.
- Certified Professionals: Fully licensed, insured, and highly trained staff.
- Local Expertise: We know the unique needs of our community.
- Customer-First Service: We guide you through every step, from testing to results.
Ready to Ensure Pharmaceutical Compliance?
Contact us today for professional pharmaceutical environmental monitoring and maintain the highest standards of patient safety. Our team is here to help you every step of the way.
Schedule Monitoring